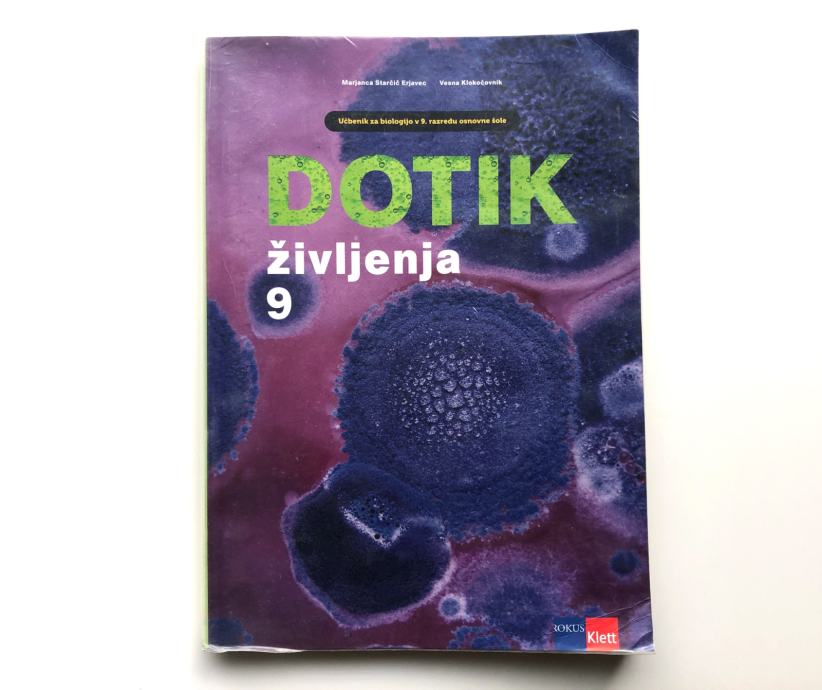

Učbeniki za 9. razred OŠ
- Cena
- 8 €
+ zaščita kupca 1,96 €
+ dostava od 2,90 €
0 € dostava na paketomatih!
Na voljo samo v mobilni aplikaciji bolha.com.

Storitev BREZ SKRBI - Denar za izdelek nakažete na nevtralni račun bolha.com. Če prejeti izdelek ni enak naročenemu ali izdelek ni bil dostavljen, vam vrnemo denar. Pred naročanjem pozorno preberite Navodila in pogosta vprašanja.
Šifra oglasa: 14394768
Osnovne informacije
- Lokacija
- Osrednjeslovenska, Domžale, Radomlje
- Stanje
- rabljeno
Opis oglasa
Prodam zelo lepo ohranjene učbenike za 9. razred. Vsi so bili oz. so še zaviti pri DZS v prozoren ovitek. Edini znaki uporabe so vogali platnice - glej slike. Sicer so popolnoma nepopisani.
Na voljo je:
ZGO - Zgodobvina učbenik, Mladinska knjiga, ISBN 978-961-01-5573-7 - 8,50 EUR
LUM - Likovna umetnost učbenik, MK, ISBN 978-961-01-5384-9 - 8 EUR
MAT - Učbenik Skrivnost števil in oblik 9, Rokus Klett, ISBN 9789612920272 - 9 EUR
MAT - Samostojni delovni zvezek 1 in 2 (dva zvezka), MK, ISBN 978-961-01-5342-9 - 9 EUR za oba skupaj
BIO - Dotik življenja 9. Rokus Klett, ISBN 9789612718640 - 10 EUR
GEO - Geografija Slovenije, učbenik 9, Modrijan, ISBN 978-961-70770-33-0
TJA oz. ENG - Touchstone 9, učbenik angleščine, Založba Tangram, ISBN 691-6239-44-9 - 10 EUR
FIZ - učbenik za fiziko za 9. razred OŠ, MK, ISBN 978-9-610164-26-5 - 10 EUR
Cena je polovico cene novega učbenika.
Prevzem je možen v Radomljah oz. okolici. Lahko pošljem po pošti po predhodnem nakazilu na moj TRR + poštnina po ceniku Pošte Slovenije. Poštnino sporočim glede na težo učbenika, cca. 4,50 eur za en kos.
Na voljo je:
ZGO - Zgodobvina učbenik, Mladinska knjiga, ISBN 978-961-01-5573-7 - 8,50 EUR
LUM - Likovna umetnost učbenik, MK, ISBN 978-961-01-5384-9 - 8 EUR
MAT - Učbenik Skrivnost števil in oblik 9, Rokus Klett, ISBN 9789612920272 - 9 EUR
MAT - Samostojni delovni zvezek 1 in 2 (dva zvezka), MK, ISBN 978-961-01-5342-9 - 9 EUR za oba skupaj
BIO - Dotik življenja 9. Rokus Klett, ISBN 9789612718640 - 10 EUR
GEO - Geografija Slovenije, učbenik 9, Modrijan, ISBN 978-961-70770-33-0
TJA oz. ENG - Touchstone 9, učbenik angleščine, Založba Tangram, ISBN 691-6239-44-9 - 10 EUR
FIZ - učbenik za fiziko za 9. razred OŠ, MK, ISBN 978-9-610164-26-5 - 10 EUR
Cena je polovico cene novega učbenika.
Prevzem je možen v Radomljah oz. okolici. Lahko pošljem po pošti po predhodnem nakazilu na moj TRR + poštnina po ceniku Pošte Slovenije. Poštnino sporočim glede na težo učbenika, cca. 4,50 eur za en kos.
Zemljevid
Opomba: prikaže se približna lokacija vašega oglasa
rokgre78
Vsi oglasi tega oglaševalca
Uporabnik je telefonsko številko preveril v državi Slovenija
Uporabnik ni trgovec in zanj ne veljajo določbe EU o varstvu potrošnikov.
- Naslov: 1235 Radomlje, Osrednjeslovenska, Slovenija
- Oglas je objavljen
- 22.06.2026. ob 07:35
- Do poteka še
- Oglas je prikazan
- 744 -krat
rokgre78
Vsi oglasi tega oglaševalca
Uporabnik je telefonsko številko preveril v državi Slovenija
Uporabnik ni trgovec in zanj ne veljajo določbe EU o varstvu potrošnikov.
- Naslov: 1235 Radomlje, Osrednjeslovenska, Slovenija